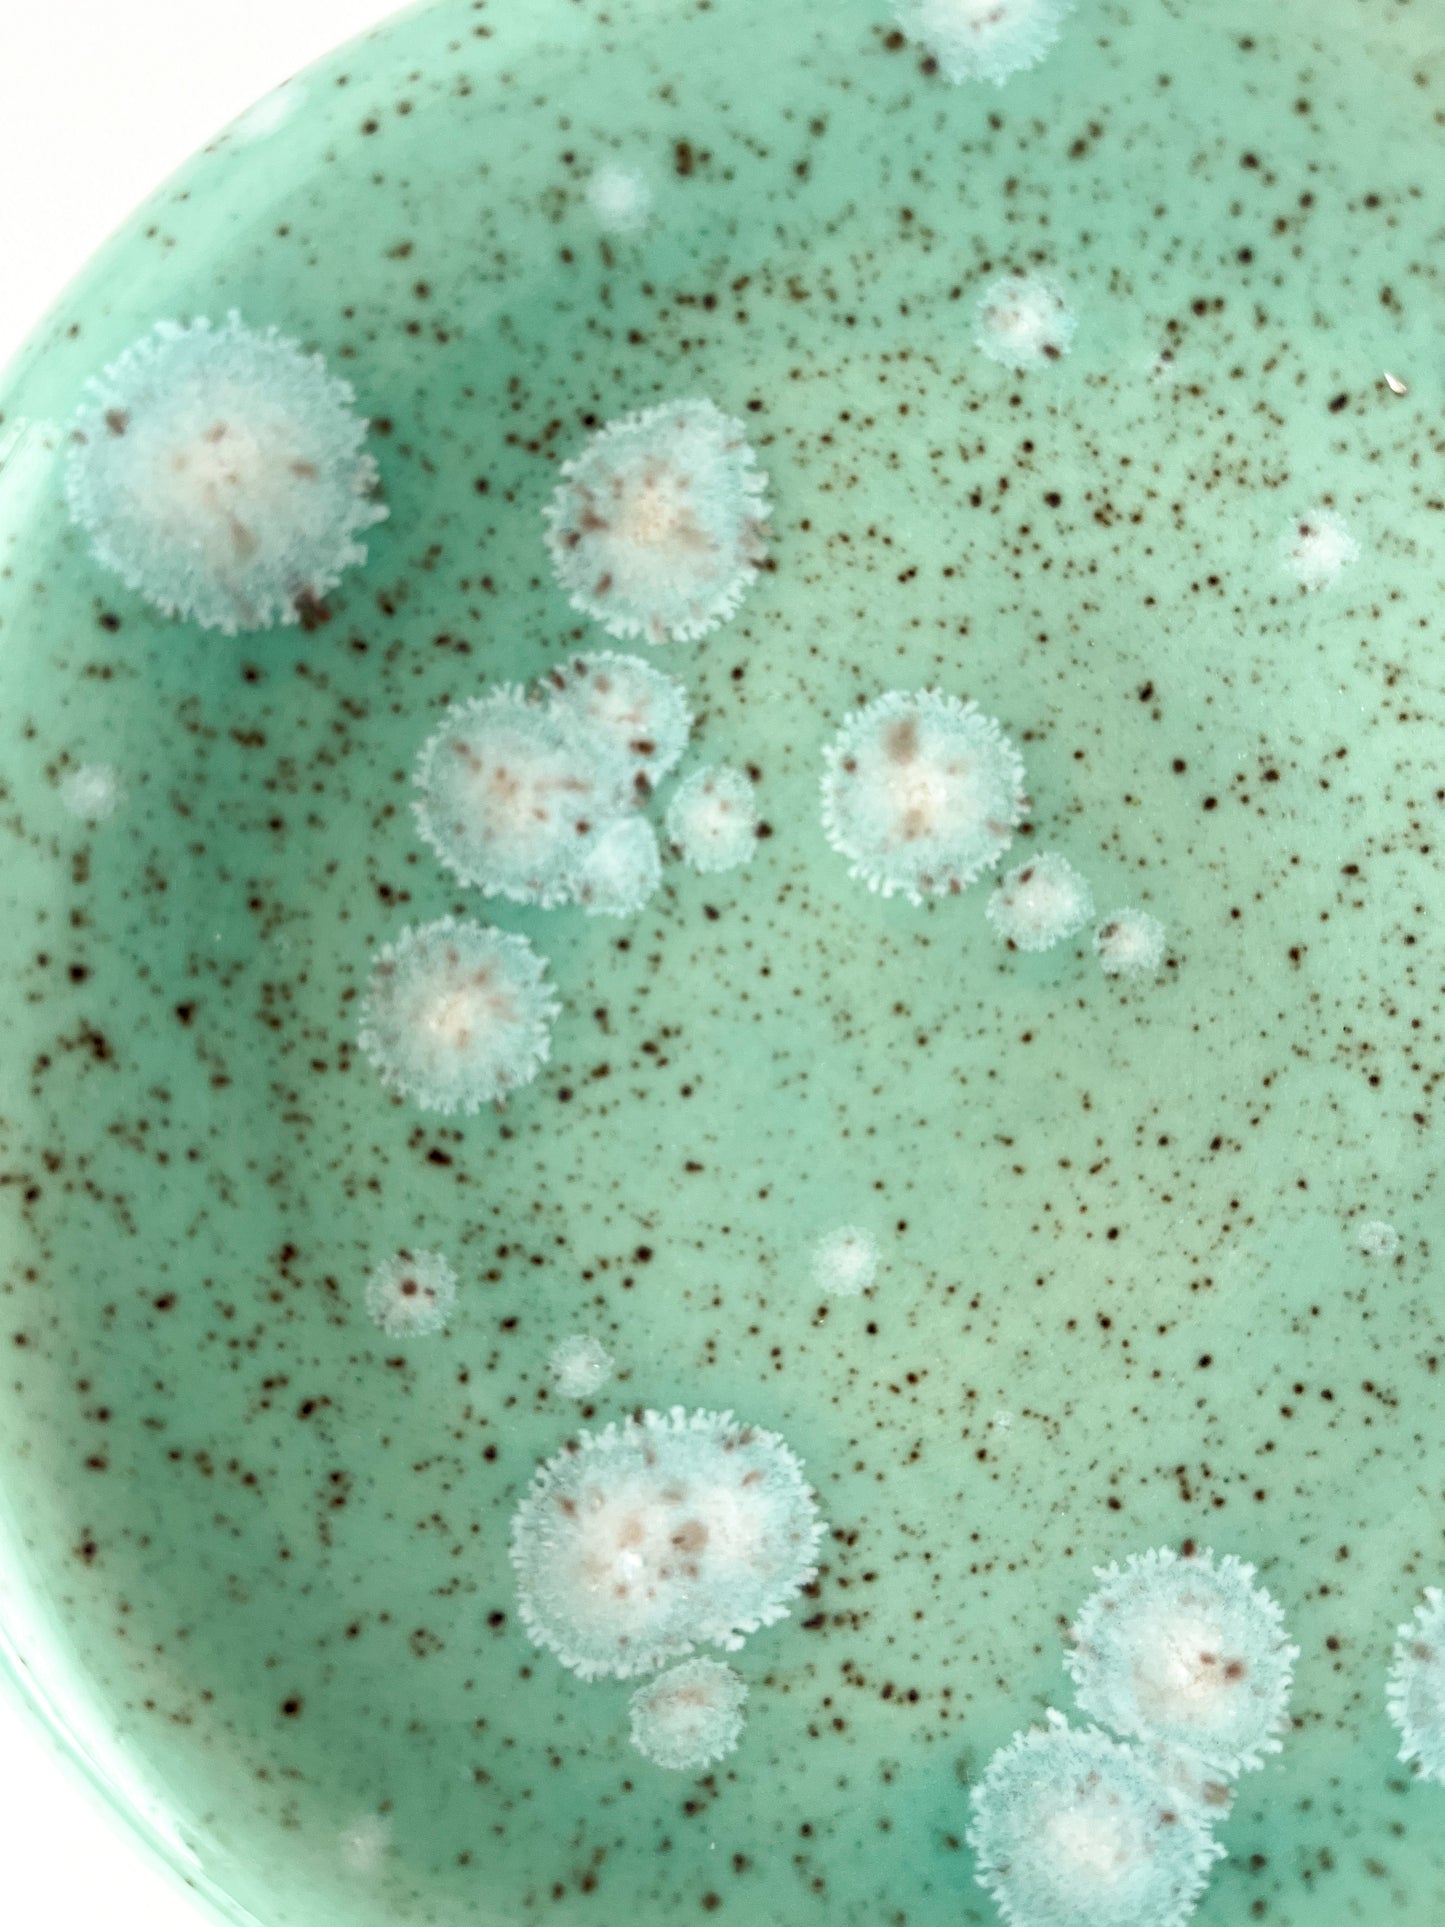
bubble trinket dish no.8

1
/
of
6
bubble trinket dish no.8
bubble trinket dish no.8
Regular price
$ 34.00 USD
Regular price
Sale price
$ 34.00 USD
Unit price
/
per
Couldn't load pickup availability
• wheel thrown on speckled clay
• approximately 6” wide by 1.5" tall
• made by kirby in seattle, wa.
• one of a kind, ships immediately
• final sale
Share